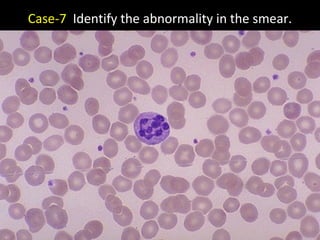
Case-7 Identify the abnormality in the smear.

This document contains several quiz cases related to disorders of leucocytes. Some key details include:
- Case 1 asks about differentiating a condition from leukemoid reaction, the chromosomal abnormality involved, and treatment drugs.
- Case 3 describes a 60-year-old male with splenomegaly and anemia.
- Case 10 lists abnormal differential count findings in a 25-year-old male with fever.
- Case 11 describes test results for a 60-year-old female with bone pain and asks for the diagnosis.
- The document provides clues to identify people, medical conditions, and drugs related to hematology. It aims to test knowledge of disorders of white blood cells